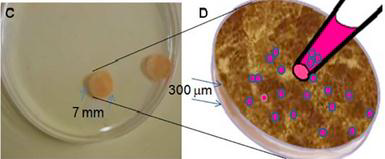

访问机构
INTERVIEW
当前位置: 首页 > 访问机构 > 访问机构——移动/医疗
以色列微型人造胰腺Betalin Therapeutics 公司治疗领域:糖尿病治疗
公司现状:临床研究
微型人造胰腺
以色列微型人造胰腺Betalin Therapeutics 公司治疗领域:糖尿病治疗
公司现状:临床研究
微型人造胰腺 以色列神经手术监测Nervio 公司临床进展:公司目前完成了两个POC,取得了90%的准确率。目前正在以色列…
以色列神经手术监测Nervio 公司临床进展:公司目前完成了两个POC,取得了90%的准确率。目前正在以色列… 以色列ironSource作为全球领先的商业化平台ironSource作为全球领先的商业化平台
以色列ironSource作为全球领先的商业化平台ironSource作为全球领先的商业化平台 以色列Incredibuild 软件开发加速技术供应商Incredibuild 是一家以色列软件开发加速技术领域的主要解决方案…
以色列Incredibuild 软件开发加速技术供应商Incredibuild 是一家以色列软件开发加速技术领域的主要解决方案… 以色列远程医疗K Health 公司K Health在纽约和特拉维夫拥有110名员工,其中包括20位医生、3…
以色列远程医疗K Health 公司K Health在纽约和特拉维夫拥有110名员工,其中包括20位医生、3… 以色列汽车检测创业公司UVeye该公司表示其技术能够发现汽车底下是否有受损区域、部件遗失或是泄露等各种异…
以色列汽车检测创业公司UVeye该公司表示其技术能够发现汽车底下是否有受损区域、部件遗失或是泄露等各种异…